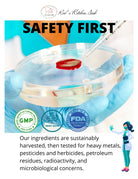
Cell Fuel 102: Organic Sea Moss, Bladderwrack & Burdock Root Herbal Blend - Red's Kitchen Sink

Cell Fuel 102: Organic Sea Moss, Bladderwrack & Burdock Root Herbal Blend
Shipping Time: Processing 1 to 3 business days, transit 2 to 5 business days.
Cell Fuel 102™ Organic Sea Moss Powder – Herbal Blend
✅ 100% Plant-Based | ✅ No Fillers or Additives | ✅ Nutrient-Dense Formula
About This Product
Cell Fuel 102™ Sea Moss Powder is an amazing herbal blend featuring Organic Irish Moss combined with two powerful botanicals: Organic Bladderwrack and Organic Burdock Root. These three ingredients have been traditionally used in natural wellness practices and are valued for their mineral content and plant-based vitality.
Simply scoop, blend, and go — no refrigeration, no prep, and no compromise on quality.
Size: 7oz (200g)
🌿 What’s Inside
- Organic Irish Moss (Chondrus Crispus) – A natural source of ocean minerals and fiber.
- Organic Bladderwrack – A brown sea vegetable traditionally valued for its iodine and trace elements.
- Organic Burdock Root – A root known in traditional herbalism for its earthy mineral content and plant compounds.
No preservatives. No fillers. No synthetic ingredients. Please note: This is an all-natural herbal blend made with organic powders, primarily from sea vegetables. It contains no added flavors or sweeteners, so it will have a distinct ocean-like taste and smell.
📦 Suggested Use
- Add 1-2 scoops to smoothies or warm drink (tea or coffee). We do not recommend using in a cool drink due to it being difficult to mix in. Blending is the best way to consume.
- Can be also added to soups or when cooking to easily mask the taste.
- Store in a cool, dry place.
- See video above for a delicious recipe that can easily mask the taste.
🔒 Why Choose Red’s Kitchen Sink?
- Crafted in small batches for quality and consistency.
- Made with Premium Wildcrafted and Organic ingredients.
- Zero synthetic preservatives or artificial flavors.
🧾 Frequently Asked Questions
Is this made from real sea moss?
Yes! This blend contains real wildcrafted sea moss (Chondrus Crispus) along with organic bladderwrack and burdock root — no synthetics or fillers.
What does it taste like?
It has a mild, earthy, and slightly oceanic flavor. Best when added to smoothies or juices to balance out the taste.
Can I mix it with hot drinks?
Yes. It's safe to use in warm teas and beverages. Some people enjoy it in hot lemon water or herbal teas.
Does it replace Sea Moss Gel?
Not exactly. It’s a powdered alternative for people who prefer dry storage, less prep time, or who want to take it on the go. Some customers use both depending on convenience.
Is it safe during pregnancy or for kids?
As with any herbal product, we recommend checking with a qualified healthcare provider before use during pregnancy, while nursing, or for children.
Want to compare Sea Moss Powder with other formats?
- Visit the Sea Moss Marketplace to see every format
- Raw Sea Moss – Ideal if you like preparing your own gel
- Sea Moss Gel – A smoother, spoonable option
- Sea Moss Capsules – Simplest if you just want a quick dose
- Sea Moss Gel Bites – Great if you prefer a bite sized format
- See Wholesale Sea Moss for larger, bulk orders
📄 FDA Disclaimer
Supplement Safety Notice: This product is intended to support general wellness and nutrition. It is not intended to diagnose, treat, cure, or prevent any disease.
Do not exceed suggested use. Consult a healthcare professional before use if you are pregnant, nursing, taking medications, or have a medical condition.
Returns: 30-day returns accepted (opened or unopened). Customer pays return shipping.
Damaged or incorrect items: Please notify us within 14 days of delivery.
Best for
- Customers who want an easy to mix sea moss option without soaking or making gel.
- People who want to add sea moss to smoothies, juices, teas, or recipes with minimal effort.
- Anyone who wants a shelf stable product that stores well and travels easily.
- Shoppers looking for a neutral tasting format that blends quickly and smoothly.
- Individuals who want more versatility than capsules but more convenience than raw sea moss.
Not ideal if
- You prefer a ready to eat gel with no mixing required.
- You dislike any hint of ocean flavor, where capsules may be a better fit.
- You want the lowest cost per serving, which raw sea moss typically offers.
- You prefer the full texture and whole food experience of raw or gel formats.
- ou want a product that does not require mixing, shaking, or blending.
Format: powder
Prep: mix into smoothies or liquids
Taste: strong; easier to blend with drinks and recipes
Shelf stable: Yes
Travel friendly: true
Allergen notes: Contains seaweed. Not a shellfish. While uncommon, some individuals may have sensitivities to seaweeds or iodine rich marine plants.
Explore other Sea Moss formats: